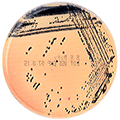
Salmonella
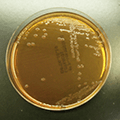
Shigella
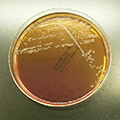
E.coliO157

微生物学的菌検査について
近年、ノロウイルスによる、また過去においては腸管出血性大腸菌O157による集団食中毒が多発しております。
このような状況下では、食品給食業務等に携わる方々における病原菌及び病原ウイルスの早期発見は必須と言えます。
また、病原性大腸菌のみならず多種にわたる腸内病原菌の検査を目的とした検査を定期化させることにより貴社の自主衛生管理の品質保証にお役に立てるものと確信いたしております。
このような状況下では、食品給食業務等に携わる方々における病原菌及び病原ウイルスの早期発見は必須と言えます。
また、病原性大腸菌のみならず多種にわたる腸内病原菌の検査を目的とした検査を定期化させることにより貴社の自主衛生管理の品質保証にお役に立てるものと確信いたしております。
検査依頼要項
1. 依頼項目
当社は、主として健常者よりの腸内病原菌保菌者の検査を行っております。
| 材料 (検体) | 糞便 |
| 目的 | サルモネラ(腸チフス、パラチフスを含む)、赤痢菌、 腸管出血性大腸菌O157、ノロウイルス |
上記項目以外の病原菌(腸管出血性大腸菌O26・O111、腸炎ビブリオ、黄色ブドウ球菌など)についての検査は別途ご相談ください。
2. 検査依頼方法

貴社の各々の事業所・営業所・出張所等出先機関ともお受けできる体制がととのっております。
当社本社までご連絡いただければ、営業担当者がお伺いしご説明申し上げます。
- 依頼書1通(当社指定のものにご記入ください)
- 検体容器に採取し、依頼書と共に担当者にお渡しください。
- 容器は担当者が持参するか郵送致します。
3. 検体採取について
当社指定の採便容器をご使用頂きます。(キャリー・ブレアー培地)
採取量は採便棒に少量つく程度(入れ過ぎないようにお願い致します)
※試料の膨張による蓋のはずれ、漏出にご注意ください。
- ノロウイルス検査につきましては専用容器をご使用ください。
- 採取量:採便棒に親指の頭くらいの量(便の量が少なすぎると正しい結果が得られない場合がございます。)
4. 検体ラベルの記載項目
氏名・検体採取年月日・委託元の名称(事業所名、テナント名など)を必ずご記入ください。
5. 検体保存について
| 腸内細菌検査 |
|---|
| 直射日光を避け、室温(1~30℃)で保存してください。できれば一週間以内に提出してください。 |
| ノロウイルス検査(LAMP法、RT-PCR法およびイムノクロマト法) |
| 冷凍(-20℃)で保存して下さい。 |
6. 検査所要時間
検査項目により異なります。主な検査内容をご参照ください。
7. 検査報告

(ご希望によりPDFのメール送信も可)
検査結果が陽性の場合、お客様ご担当者に至急電話にてご報告致します。
8. 陽性の判定基準
- 「大腸菌性状(+)血清凝集 O157/O26/O111 (+)ベロ毒素(+): O157/O26/O111 陽性」
- 「赤痢菌性状(+)血清凝集(+):赤痢菌陽性」
- 「サルモネラ菌性状(+)血清凝集(+):サルモネラ菌陽性」
- 「腸炎ビブリオ性状(+):腸炎ビブリオ陽性」
- 「黄色ブドウ球菌性状(+):黄色ブドウ球菌陽性」
Salmonella
Shigella
E.coliO157
微生物の主な検査内容
腸内細菌検査(検便) 当日受付15:30まで
| ◎セット | |
| 検査項目 | 報告日数 |
| 赤痢菌+サルモネラ菌+腸チフス・パラチフスA | 3~5日 |
| 上記セット + O157 | 3~5日 |
| ◎単項目 | |
| 検査項目 | 報告日数 |
| 腸管出血性大腸菌O26、O111 | 3~5日 |
| 黄色ブドウ球菌 | 3~5日 |
| 腸炎ビブリオ | 3~5日 |
ノロウイルス検査(検便) 当日受付 午前11:00まで
| 検査項目 | 報告日数 |
| 遺伝子増幅反応検査 (LAMP法) | 1~3日 |
| 遺伝子増幅反応検査 (RT-PCR法) | 1~3日 |
| ノロウイルス抗原検出検査(イムノクロマト法) | 1~2日 |

